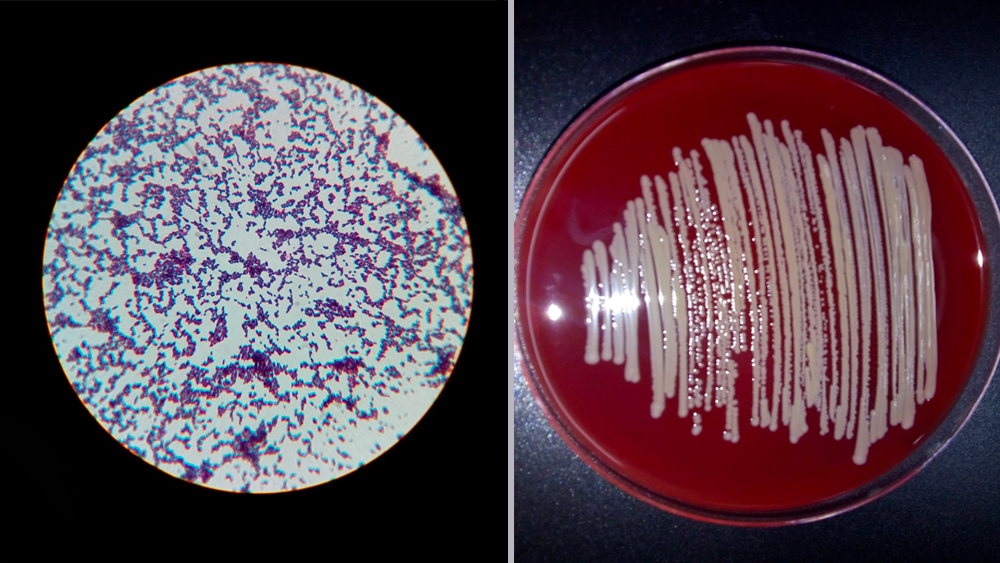

হওয়ার কথাই নয়। তবু কেন এগজিমার মতো ভয়ঙ্কর চর্মরোগের শিকার হতে হয় ভারতের শিশুদের?
সেই প্রশ্নের উত্তর মিলল। এই প্রথম। এগজিমা রোগের চিকিৎসায় একটি নতুন পথের সন্ধান দিলেন বেহালার সখেরবাজারের শৌভিক মুখার্জি।
দেখালেন, এগজিমার জন্য শুধু আমাদের জিনের রদবদলই দায়ী নয়, যথেষ্টই ভূমিকা রয়েছে একটি ক্ষতিকারক ব্যাক্টিরিয়ারও। মোদ্দা কথায়, বিষয়টা একতরফা নয়। দায় রয়েছে আমাদের জিন ও একটি ব্যাক্টিরিয়া, দু’তরফেরই।
এগজিমার নতুন ওষুধ বেরনোর পথ খুলতে পারে
এর ফলে, আগামী দিনে এগজিমার আরও কার্যকরী ওষুধ আবিষ্কারের সম্ভাব্য পথটা খুলে গেল বলে মনে করছেন বিজ্ঞানী ও চিকিৎসদের একাংশ। কারণ, এত দিন এগজিমার ওষুধ বানানো হতো আমাদের জিনের ঘন ঘন রদবদলের (‘মিউটেশন’) কথা মাথায় রেখেই।
গবেষকদলে কল্যাণীর ‘ন্যাশনাল ইনস্টিটিউট অব বায়োমে়ডিক্যাল জিনোমিক্স (এনআইবিএমজি)’-এর সহকারী অধ্যাপক শৌভিক মুখার্জি ছাড়াও রয়েছেন বিশিষ্ট জিনতত্ত্ববিদ অধ্যাপক পার্থপ্রতিম মজুমদার। রয়েছেন কলকাতার মেডিক্যাল কলেজ হাসপাতালের চর্মরোগ বিশেষজ্ঞ দেবব্রত বন্দোপাধ্যায় এবং কল্যাণীর জওহরলাল নেহরু মেমোরিয়াল (জেএনএম) হাসপাতালের চর্মরোগের বিভাগীয় প্রধান নিলয় সিংহ।


দেবব্রত বন্দোপাধ্যায় (বাঁ দিক থেকে), নিলয় সিংহ, শৌভিক মুখার্জি, পার্থপ্রতিম মজুমদার, শঙ্খ নাথ ও নয়না কুমারী, (ইনসেটে) মতামতে ভবতোষ দাস।
গবেষণাপত্রটি প্রকাশিত হতে চলেছে আন্তর্জাতিক বিজ্ঞান-জার্নাল ‘ফ্রন্টিয়ার্স ইন সেলুলার অ্যান্ড ইনফেকশন মাইক্রোবায়োলজি’-তে। তা ইতিমধ্যেই অনলাইন হয়েছে।
এগজিমা কী? কেন হয়?
এগজিমা একটি ভয়ঙ্কর চর্মরোগ। এর ফলে ত্বকে লাল রঙের ‘র্যাশ’ বেরয়। খুব চুলকানি হয়। প্রদাহ হয়। চিকিৎসাবিজ্ঞানে যার নাম- ‘অ্যাটোপিক ডার্মাটাইটিস’। পরিবেশের (‘এনভায়রমেন্ট’) সঙ্গে আমাদের ত্বক ঠিক ভাবে মানিয়ে নিতে না পারলেই এগজিমা হয়।
শিশুদের তিন মাস বয়স থেকেই এই রোগ হতে দেখা যায়। মোটামুটি ৫ বছর বয়স পর্যন্ত শিশুদের এই রোগে আক্রান্ত হতে দেখা যায়। বয়স বাড়ার সঙ্গে সঙ্গে র্যাশ মিলিয়ে যায়। পরিবেশের সঙ্গে মানিয়ে নেওয়ার ক্ষমতা তত দিনে আমাদের শরীর অর্জন করতে পারে বলে। খুব কম ক্ষেত্রে ঘটলেও অনেক সময় ১৮ বছর বয়সেও এই রোগ ফিরে আসতে দেখা গিয়েছে।
এটাও দেখা গিয়েছে, তুলনামূলক ভাবে অনেক স্বচ্ছ্বল বা শীতের দেশগুলির শিশুরা এই রোগে বেশি আক্রান্ত হয়। তারা অন্য শিশুর সঙ্গে মেলামেশা কিছুটা কম করে বা শীতের জন্য বেশি জামাকাপড় পরে বলে।
প্রতি ৫টি শিশুর একটির হয় এগজিমা
শৌভিকের কথায়, ‘‘ভারতেও বহু শিশু আক্রান্ত হয় এই চর্মরোগে। বিশ্বে প্রতি পাঁচটি শিশুর মধ্যে একটি আক্রান্ত হয় এগজিমায়।’’
আন্তর্জাতিক বিজ্ঞান-জার্নাল ‘অ্যানালস্ অব নিউট্রিশান অ্যান্ড মেটাবলিজম’-এ প্রকাশিত একটি গবেষণাপত্র জানাচ্ছে, বিশ্বে ২০ শতাংশ শিশুরই এগজিমা হয়। এই রোগে আক্রান্ত হন ৩ শতাংশ প্রাপ্তবয়স্কও।


এগজিমা। পায়ে।
‘ইন্ডিয়ান জার্নাল অব ডার্মাটোলজি’র ২০১৯ সালের মে-জুন সংখ্যায় প্রকাশিত একটি গবেষণাপত্র জানাচ্ছে, ভারতে শিশুদের যত রকমের চর্মরোগ হয় তার ২৯.৯ শতাংশই এগজিমা। গড়ে সাড়ে ৪ বছর বয়সে শিশুদের এই রোগে আক্রান্ত হতে দেখা যায়। হারের নিরিখে এগিয়ে শিশুপুত্ররা। ২.২৫টি শিশুপুত্র এগজিমায় আক্রান্ত হলে গড়ে সাড়ে ৪ বছর বয়সে ১টি শিশুকন্যা আক্রান্ত হয় এগজিমায়। শীতে এই রোগে আক্রান্ত হওয়ার আশঙ্কা বাড়ে। সারা বছরে যত ভারতে যত শিশুর এগজিমা হয় তার ৬২ শতাংশই আক্রান্ত হয় শীতে।
মূল শত্রু একটি ব্যাক্টিরিয়া
শৌভিক জানাচ্ছেন, তাঁরা দেখেছেন হওয়ার কোনও কারণ না থাকলেও ভারতীয় শিশুরা এই রোগে আক্রান্ত হয় মূলত একটি ব্যাক্টিরিয়ার জন্য। তার নাম- ‘স্ট্যাফাইলোকক্কাস অরিয়াস’।
শুষ্ক ও আর্দ্র ত্বক: কেন হয়?
আমাদের ত্বকের আর্দ্রতার জন্য দায়ী মূলত একটি জিন। ‘এফএলজি’। এই জিন একটি বিশেষ ধরনের প্রোটিন তৈরি করে। তার নাম- ‘ফিলাগ্রিন’। এই প্রোটিনই আমাদের ত্বককে আর্দ্র করে তোলে।
কিন্তু এফএলজি জিনের খুব বেশি মিউটেশন হলে, সেই জিনগুলি খুব দ্রুত হারে বদলাতে থাকলে ফিলাগ্রিন প্রোটিন পর্যাপ্ত পরিমাণে তৈরি হয় না। অথবা ওই প্রোটিন তৈরি হওয়া একেবারেই বন্ধ হয়ে যায়। আর তখনই আমাদের ত্বক শুকনো, খসখসে হয়ে যায়। ত্বকে লাল রঙের ‘র্যাশ’ বেরতে থাকে। যা থেকে প্রদাহ হয়। এই সবের জন্য নানা ধরনের চর্মরোগের জন্ম হয়। এগজিমা তার অন্যতম।
জিনের মিউটেশনগুলির একটিও হয় না ভারতে, তবু…
শৌভিক বললেন, ‘‘এর আগে এটা জানা ছিল না, এফএলজি জিনের খুব দ্রুত হারে ঘন ঘন অন্তত যে ৮টি মিউটেশন দেখা যায় অন্যান্য দেশে, ভারতে সেই মিউটেশনগুলির একটিও হয় না। এটা আমরাই প্রথম দেখলাম। তখনই আমাদের মনে প্রশ্ন উঠল, ভারতে এফএলজি জিনের ৮টি মিউটেশনের একটিও না হওয়া সত্ত্বেও এ দেশের শিশুরা কেন এত বেশি সংখ্যায় এগজিমায় আক্রান্ত হয়? এই প্রশ্নের উত্তর খুঁজতেই আমরা গবেষণা শুরু করি ৪ বছর আগে। ২০১৬-য়।’’


এগজিমা। হাতে।
বেহালার ঠাকুরপুকুর বিবেকানন্দ কলেজ থেকে বিএসসি করার পর শৌভিক মাস্টার্স করেন কলকাতা বিশ্ববিদ্যালয়ের বালিগঞ্জ সায়েন্সে কলেজে। পিএইচডি বরাহনগরের ইন্ডিয়ান স্ট্যাটিস্টিক্যাল ইনস্টিটিউট (আইএসআই) এবং এনআইবিএমজি-তে। তাঁর পোস্ট ডক্টরাল কাজের কিছুটা হয়েছিল স্পেনে। ৪ বছর আগে শৌভিক যোগ দেন কল্যাণীর এনআইবিএমজি-তে।
সহায়তায় মেডিক্যাল কলেজ, ইউনিলেভার
এ ব্যাপারে গবেষকদের সহায়তা করেছেন কলকাতার মেডিক্যাল কলেজের চর্মরোগ বিশেষজ্ঞ চিকিৎসক দেবব্রত বন্দোপাধ্যায় ও কল্যাণীর চিকিৎসক নিলয় সিংহ। মেডিক্যাল কলেজ থেকে চর্মরোগীদের ত্বকের নমুনা সংগ্রহ করা হয়েছে। গবেষণায় সহায়তা করেছে ‘ইউনিলেভার’-এর মতো সংস্থাও।
কী দেখেছেন গবেষকরা?
অন্যতম মূল গবেষক বিশিষ্ট জিনতত্ত্ববিদ পার্থপ্রতিম মজুমদারের কথায়, ‘‘স্ট্যাফাইলোকক্কাস অরিয়াস’ নামে একটি ব্যাক্টিরিয়া এমন কয়েকটি এনজাইম (আদতে প্রোটিন) তৈরি করে যা আমাদের শরীরে থাকা ফিলাগ্রিন প্রোটিনটিকে ভেঙে দেয়। ওই ব্যাক্টিরিয়া আমাদের ত্বকে বাসা বাঁধলে মানবশরীরে ফিলাগ্রিন প্রোটিন ভেঙে যায়। তার ফলে আমাদের আর্দ্র ত্বক উত্তরোত্তর শুকনো, খসখসে হয়ে পড়ে।’’
আমাদের ত্বকের পক্ষে উপকারী ও ক্ষতিকারক ব্যাক্টিরিয়াদের জিনোম বিশ্লেষণ করে গবেষকরা আরও একটি ব্যাক্টিরিয়ার হদিশ পেয়েছেন। ‘স্ট্যাফাইলোকক্কাস হোমিনিস’।
‘‘এই স্ট্যাফাইলোকক্কাস হোমিনিস’ ব্যাক্টিরিয়াটি আবার ক্ষতিকারক স্ট্যাফাইলোকক্কাস অরিয়াস ব্যাক্টিরিয়াটিকে মেরে ফেলে। তাই আমাদের ত্বকে কখনওই এক সঙ্গে এই দু’টি ব্যাক্টিরিয়াকে দেখা যায় না’’, বলছেন শৌভিক।
গবেষণার অভিনবত্ব
পার্থপ্রতিম জানাচ্ছেন, এই গবেষণাটি যে পদ্ধতিতে করা হয়েছে তার নাম- ‘মাইক্রোবায়োম সিকোয়েন্সিং’। ভারতে একেবারেই নতুন বলা যায় এই পদ্ধতিকে।
পার্থপ্রতিমের কথায়, ‘‘এগজিমা রোগীর ত্বকের নমুনা পরীক্ষা করে যে ১৫০টিরও বেশি ব্যাক্টিরিয়ার জিনোম পেয়েছিলাম আমরা মাইক্রোবায়োম সিকোয়েন্সিং পদ্ধতিতে সেগুলি একই সঙ্গে পরীক্ষা করে দেখা হয়েছে। এই পদ্ধতিতে কোনও একটি ব্যাক্টিরিয়ার জিনোম আলাদা ভাবে পরীক্ষা করা সম্ভব নয়। তার জন্য প্রয়োজন হয় খুব জটিল গাণিতিক বিশ্লেষণ।’’
হোমিনিস বন্ধু, অরিয়াস শত্রু
শৌভিক জানাচ্ছেন, আমাদের ত্বক শুকনো হলেই সেই ত্বকে প্রচুর পরিমাণে ক্ষতিকারক স্ট্যাফাইলোকক্কাস অরিয়াস ব্যাক্টিরিয়াটির হদিশ মেলে। আর যাঁদের ত্বক আর্দ্র, তাঁদের ত্বকে এই ব্যাক্টিরিয়া একেবারেই নেই। বরং রয়েছে একটি উপকারী ব্যাক্টিরিয়া। স্ট্যাফাইলোকক্কাস হোমিনিস।
‘‘এরা আবার ক্ষতিকারক ব্যাক্টিরিয়াটিকে মেরে ফেলে। তাই আমাদের ত্বকে কখনওই এদের এক সঙ্গে দেখা যায় না’’, বলছেন শৌভিক।
গবেষকরা কলকাতার মেডিক্যাল কলেজ হাসপাতাল থেকে মোট ৮০ জন চর্মরোগীর ত্বকের নমুনা সংগ্রহ করেছিলেন। নিলয়ের কথায়, ‘‘কোনও গবেষণার জন্য কতটা নমুনা সংগ্রহ করা হবে সেটা পরিসংখ্যানবিদরাই ঠিক করে দেন। ফলে, আমি বলব, গবেষণার পক্ষে এই পরিমাণ নমুনা পর্যাপ্তই ছিল।’’
এজেন্ট, হোস্ট ও এনভায়রনমমেন্ট
তবে শুধুই আমাদের (‘হোস্ট’) জিনের রদবদল আর কোনও ব্যাক্টিরিয়ার (‘এজেন্ট’) আগ্রাসী ভূমিকাই যে কোনও সংক্রমণের একমাত্র নিয়ন্ত্রক, তা কিন্তু নয়। তা হলে সেই সংক্রমণের প্রকৃতি বোঝা আর তা ঠেকানোর সঠিক পথ বের করা যাবে না।
পরিবেশের ভূমিকাও খতিয়ে দেখা হয়েছে
নিলয় বলছেন, ‘‘করোনাভাইরাসের কথাই ধরুন। সে নিজে ‘এজেন্ট’। যার শরীরে সে ঢোকে সে ‘হোস্ট’। এর পাশাপাশি রয়েছে ‘এনভায়রনমেন্ট’ও। তাই এক এক দেশে করোনা সংক্রমণ বা মৃত্যুর হার এক এক রকম হচ্ছে। তাই কোনও রোগকে চেনা ও বোঝার জন্য এজেন্ট, হোস্ট আর এনভায়রনমেন্ট, এই তিনটিকেই বোঝার প্রয়োজন। এগজিমার ক্ষেত্রেও এই নিয়মের ব্যাতিক্রম ঘটে না।’’

চর্মরোগীদের ত্বকের নমুনা থেকে পাওয়া ব্যক্টিরিয়াদের জিনোম।
তাই এই গবেষণায় পরিবেশের ভূমিকাও খতিয়ে দেখা হয়েছে। আমাদের মতো তাপমাত্রা ও আবহাওয়ার দেশে ত্বক বেশি ক্ষণ আর্দ্র থাকে না। শুকিয়ে গেলেই সেই ত্বকে ক্ষতিকারক স্ট্যাফাইলোকক্কাস অরিয়াস ব্যাক্টিরিয়ার বাসা বাঁধার সম্ভাবনা বেড়ে যায়, জানালেন পার্থপ্রতিম।
ভারতে কি স্ট্যাফাইলোকক্কাস অরিয়াস বেশি ভয়ঙ্কর?
ফরিদাবাদের ‘ট্রান্সলেশনাল হেল্থ সায়েন্স অ্যান্ড টেকনোলজি ইনস্টিটিউট (টিএইচএসটিআই)’-এর অধ্যাপক ভবতোষ দাসের বক্তব্য, এটি অত্যন্ত গুরুত্বপূর্ণ গবেষণা। এর থেকে সম্ভবত এটাও বোঝা গেল, ভারতে যে স্ট্যাফাইলোকক্কাস অরিয়াস ব্যাক্টিরিয়া সম্প্রদায় রয়েছে, তা উন্নত পশ্চিমী দেশগুলির বায়ুমণ্ডলে থাকা এই ধরনের ব্যাক্টিরিয়াদের থেকে আরও বেশি ভয়ঙ্কর। কারণ, অনেক বেশি পরিমাণে দূষিত আমাদের দেশের বায়ুমণ্ডলে এই ধরনের ব্যাক্টিরিয়ার সঙ্গে আমাদের ত্বকের পরিচয় নতুন হতে পারে না। তার মানে, এই ধরনের ব্যাক্টিরিয়ার সঙ্গে দীর্ঘ পরিচয়ের সূত্রে এদের প্রতিরোধ করার ব্যবস্থাও আমাদের শরীরে এত দিনে গড়ে ওঠার কথা। তার পরেও ভারতে এগজিমা রোগীর সংখ্যা যে ভাবে বাড়ছে তাতে এই প্রশ্নটা উঠতেই পারে স্ট্যাফাইলোকক্কাস অরিয়াস ব্যাক্টিরিয়া কম দূষিত পশ্চিমী দেশগুলির চেয়ে ভারতে বেশি ভয়ঙ্কর হয়ে উঠেছে কি? হয়তো সে জন্যই চেনা শত্রু হলেও আমাদের দেহের প্রতিরোধী ব্যবস্থা তাকে ততটা রুখতে পারছে না।
ছবি সৌজন্যে: ন্যাশনাল ইনস্টিটিউট অব বায়োমে়ডিক্যাল জিনোমিক্স (এনআইবিএমজি), কল্যাণী।











